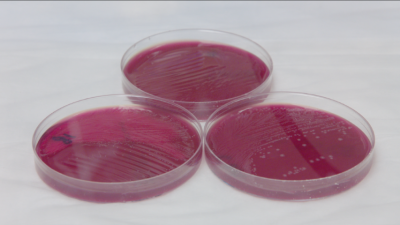

Hogyan lesz a linzer karikából márka Japánban?
Felfedezések egy ajándékba kapott kekszes doboz felett. Néhány gondolat a lekváros linzer karikáról és a…read more→

Felfedezések egy ajándékba kapott kekszes doboz felett. Néhány gondolat a lekváros linzer karikáról és a…read more→

Gondolatok külhonból, távol a magyar valóságtól. Csizmadia Ervin politológus, a Méltányosság Politikaelemző Központ igazgatójának a…read more→

Itadaki Ryutaro történész, egyetemi tanár gondolatai alapján. Nemrégiben egy szörnyű eset rázta meg Kavaszakit, Tokió…read more→

2022. július 8-án, helyi idő szerint délelőtt fél 12-kor két lövés érte Abe Sindzó volt…read more→

Cseh Dávid dramaturg, esztéta és műfordító új darabjának apropóján „Szélvész után is szép vagy” -…read more→

A történet ezúttal nem a Szovjetúnióban játszódik, nem arról van szó, hogy Sztálin elvtárs parancsba…read more→

Babona és vallás, jó és rossz, ördög és tündér, démonok, szellemek alvilág és mennyország. Szeretjük…read more→

Manapság mindenki történetet mesél. Vagy legalább próbál, hiszen ez kell a boldoguláshoz – mondják sokan.…read more→

A saját ház imidzse Tokióban vagy a metropolisz környékén egyre halványabb, nem veszi magát rá…read more→

Japánban az emberek sietnek. Nem is csak sietnek, rohannak – ezzel nem mondtam semmi újdonságot,…read more→

Véget ért a Heiszei korszak, melyet egy új császári éra, a Reiwa követ. A globalizáció…read more→

Az utóbbi időben rengeteg magyar oldal is foglalkozik/ foglalkozott vagy épp megemlítette Kondó Marie japán…read more→

Nagyon vártam, hogy földrengés is legyen az alatt a pár nap alatt, amíg az RSOE…read more→

Erre a találós kérdésre Ön meg tud felelni? A szervezet nevének rövidítése négy betű és…read more→

Tizenötezer négyszáz japán polgár gyűlt össze a tokiói császári palota előtt 2019. január 2-án, hogy…read more→

Szugihara Szatomi, az Aszahi Simbun nevű japán napilap újságírója személyes élményei alapján számol be egy…read more→

A nemi identitás és a tudatos “másság” rejtelmei c-ű cikk folytatása Ez az írásom többek…read more→

Esetek, történetek és jelenségek a régi Japánból A külföld által ismert kép a modern, mai…read more→

Helyszíni jelentés a boros pohár melletti nosztalgiázáson túl a japán-magyar kapcsolatok további fejlesztésének lehetőségeiről. 1990.…read more→

Első kézből- helyszíni beszámoló a magyar résztvevők közreműködésével A tavasz első meleg napsugarai február végén,…read more→

Az állatvilág evolúciójával szemben az emberiség egyik kimagasló érdeme, hogy mindenekelőtt az agyműködését fejlesztette tökélyre.…read more→
Ha a csont a fiatalságunk záloga, akkor a bél testünk immunrendszerének „főhadiszállása”! Ki ne szeretne…read more→

A 82 éves Mácsán valódi arca és üzenete magyarul a magyar olvasók számára Tavaly a…read more→

Veszélyben a japán termálfürdők köré épült hagyományos vendégházak többsége Hogy a veszedelem már a végzettel…read more→

…avagy egy kulcsfontosságú vitamin a stroke, az elbutulás, a depresszió és a rák megelőzéséhez Elcsépelt…read more→
És Ön mit mond?